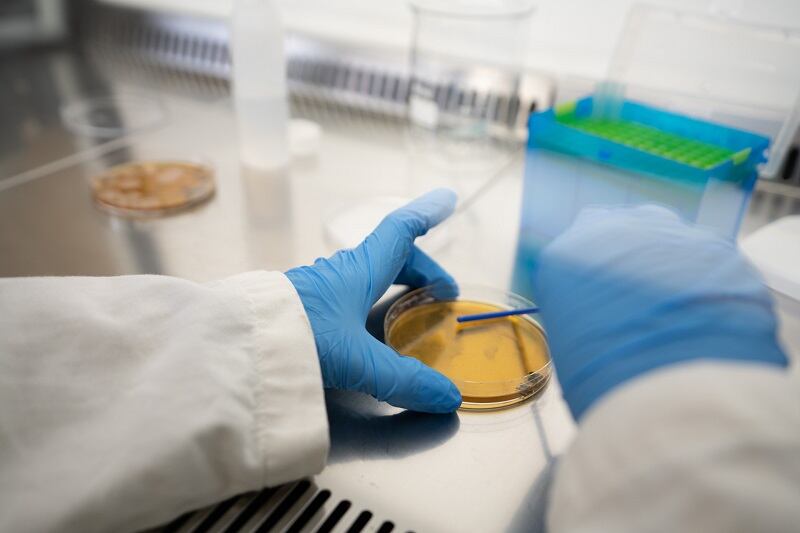

'Urine could save the world'... The start-up turning pee into greener, cheaper fertilizer
A French start-up has unveiled a urine-based fertilizer to limit the use of chemical ones and make use of valuable nutrients lost when we flush. Toopi Organics claims the solution has many environmental benefits and is cheaper for farmers.

